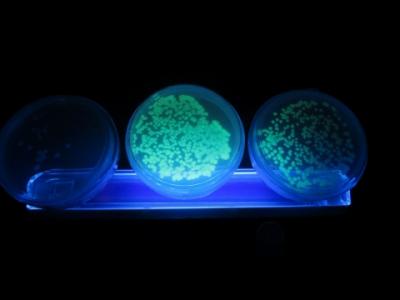

活動
サイエンスダイアログ
2月3日(水)と4日(木)に、「サイエンスダイアログ」が実施されました。これは、海外から日本の大学に来て研究している若手研究者をお招きし、大学での研究内容を英語でレクチャーしてもらう内容のものです。3日は2年理数科、4日は1年理数科対象に実施しました。
2年理数科対象
講師:Junie jhon M. VEQUIZO 博士(信州大学/環境・エネルギー材料科学研究所)
研究内容:高性能光触媒の実現を目指した反応機構の解明
光触媒について、TiO2などの効果やその他の触媒おける効果について
説明していただきました。
1年理数科対象
講師:Xiaofeng YIN 博士 (東京大学・大学院理学系研究科)
ひまわりの種の配列には規則性があり数式で表すことができる(フィボナッチ数列)
といった内容について説明していただきました。


詳しくは、arkheをご覧下さい。
ジオサイエンス連携講座②
2月3日(水)に、1年理数科対象の「ジオサインス連携講座」を実施しました。2回目となる今回は、信州大学名誉教授の鈴木啓助先生を講師にお招きし、「地球温暖化と地域での応答」という内容で講義をしていただきました。様々なデータや資料を使って、今現在地球規模で起こっている事象について分かりやすく講義をしていただきました。
詳しくは、arkheをご覧ください。
バイオサイエンス連携講座
1月29日(金)に、1年理数対象の「バイオサイエンス連携講座」が実施されました。毎年、生物分野で研究されてる方をお招きして講義を行っています。今年は、国立研究開発法人森林研究・整備機構 森林総合研究所 野生動物研究領域 領域長 岡 輝樹 氏にお越しいただき、「ツキノワグマはブナの夢を見るか?Wildlife Management」というテーマで講義をしていただきました。ブナが大豊作の翌年は凶作となるため、クマが出没しやすくなるなど、ブナとクマの関係を、様々なデータからレクチャーしていただくなど、とても興味深い内容でした。
また、附属中学2年生にも「VSニホンジカ あくなき闘いを終えるには」というテーマでご講義いただき、とても楽しく聴かせていただきました。
詳しくは、arkheをご覧下さい。
アカデミックサイエンス化学連携講座
1月27日(火)に、2年理数科対象の「アカデミックサイエンス化学連携講座」が実施されました。毎年、信州大学名誉教授の東原秀和先生に「炭素の化学」と題して講義をしていただいています。グラフェンやフラーレンなどの分子模型を作成しながら、炭素結合(σ結合やπ結合)について学び、生徒も模型作りに夢中になっていました。現在注目されているカーボンナノチューブ(CNT)のなどの最新情報についても分かりやすく説明していただきました。
詳しくは、arkheをご覧管ください。
ウニの発生観察教室
1月23日(土)に、「ウニの発生観察教室」を実施しました。これはSSH事業の「地域との連携」に関するプログラムの1つで、例年近隣の小学校に案内を出し、小学生5・6年生を対象に実施しているものです。昨年はウニが不漁だったため実施できず、今年は新型コロナの影響で実施できるか心配されましたが、参加人数を減らし、密を避け、感染予防を徹底しての実施となりました。
実施にあたっては、1年理数科の生徒や理化班の生徒がアシスタントとなってサポートし、小学生に優しくアドバイスをする形で実施し、とてもチームワークよく取り組むことができました。
バフンウニの卵や精子の放出の様子から、受精する様子までリアルタイムで観察し、あらかじめ用意してあった卵割のサンプルやプルテウス幼生を顕微鏡で観察しました。みなさん熱心に観察したりスケッチをして、ウニの発生の神秘さにひかれていました。
詳しくは、arkheをご覧下さい。
一人一研究 クラス発表会
1月15日(金)・18日(月)の2日間にわたり、1学年が取り組んできた「一人一研究」の発表会を、クラス内で実施しました。11月の中間発表会でのアドバイスを参考に研究をまとめ、今回の発表に臨みました。
グラフや表を用いて説明をしたり、実際に実験している様子の画像などを使って、分かりやすく説明している様子がありました。さらに、どのクラスも活発に質問をしてより深く理解しようとする姿勢が印象的でした。
今回の発表で、特に良かった各クラス代表2名が、3月の全体発表に臨みます。
詳しくは、arkheをご覧下さい。
和歌山県データ利活用コンペティション
12月19日(土)に、和歌山県のデータ利活用推進センターを会場に、「第4回 和歌山県データ利活用コンペティション」の最終審査が行われました。11月の一次審査を通過した1年理数科の生徒が参加し、プレゼンテーションを行い、見事「政策アイデア賞」を受賞しました。
和歌山県賞 「政策アイデア賞」(高校生の部)
「豊かな自然を生かして~ドローン&ジビエで人を呼び寄せろ~」
信州サイエンスキャンプ
12月19日(土)に、「信州サイエンスキャンプ」が開催されました。これは、課題研究合同研修会と全国総合文化祭の県予選会を兼ねて実施しているもので、本校からも理化班や課題研究班が参加し、これまでの研究の成果を発表しました。昨年は理化班の研究が最優秀賞を受賞し、全国総文祭に出場しましが、今年は残念ながら全国への切符は手にできませんでいた。でも、助言者からの貴重なアドバイスは、今後の研究の深まりに効果があると感じたようです。
また、信州大学教育学部教授の伊藤冬樹氏による「調べ学習から科学的な研究へ」という講義も行われ、課題研究を進めるうえで大切な事を学びました。
参加生徒
全国総文祭県予選会


詳しくは、arkheをご覧下さい。
ジオサイエンス連携講座
12月11日(金)に、1年理数科対象の「ジオサイエンス連携講座」を実施しました。講師に、信州大学理学部教授の大塚勉先生をお迎えし、「信州で地質学を学ぶこと」をテーマに講義をしていただきました。
信州大学の紹介を理学部地質系を中心にしていただき,日本列島の骨格(付加体の研究),地震災害への対応,活断層の研究の順で講義が行われ,最後に今回の台風19号の災害に関係して,長野盆地の地形についての教えていただきました。立体視鏡を用いた変動地形の具体的な読み方も教わり、楽しみながら学ぶ事ができました。
詳しくは、arkheをご覧下さい。
バイオサイエンス実習
1年理数科「バイオサイエンス」での実習として「大腸菌形質転換」の実験を行いました。BioRad社の実験キットを用いて、オワンクラゲ由来の緑色蛍光タンパク質遺伝子(組換えプラスミド)を導入して大腸菌を「光る大腸菌」に形質転換させました。実験は2日に分けて行われ、2時間目の今日は、ブラックライトを照射して、大腸菌が光るか確認しました。簡単に形質転換ができることに驚いていた様子でした。
日本数学A-lympiad 参加
これは、金沢大学の主催しで「世界とつながりより良い社会を築くため、数学を活用して現実課題を解決する能力」を競う目的で実施されているものです。
今年度のテーマは、スキージャンプワールドカップの結果データが与えられ、様々な条件を考慮しながら「妥当性のある順位の付け方を考える」「それを元に新しい条件を設定した大会を創設する」でした。
参加生徒
2年7組(理数科) 市河俊弥 近藤雄太 田中光 渡邊翔太
結果は、12月下旬に発表され、成績優秀チームはオランダで開催される「Math A-lympiad」に、日本代表として参加します。
パソコン甲子園2020 全国大会
11月14日(土)に、「パソコン甲子園2020」の全国大会がオンラインで実施され、本校からは2名が参加し、「プログラミング部門」で競いました。
予選は9月に実施され、長野県代表として本選出場を決め、今回の本選出場となったものです。
チーム名『TeamPython』 伊香賀 太一 長﨑 大 (2名1チーム)
参加校は、開成高校・灘高校・麻布高校・筑波大附属駒場高校など強豪校ばかりでしたが、一時は10位代まで順位を上げるなど2人とも大健闘しました。
残念ながら、上位入賞は果たせませんでしたが、全国のレベルを知って良い経験になったようです。
詳しくは、arkheに掲載します。
「科学の甲子園」 長野県予選
コンテスト当日は、実技競技が時間内に終了せず、成績が決まらないままコンテストが終了し、先日賞状と共に結果が届きました。
主な成績は以下の通りです。
結果 総合成績 準優勝 屋代Bチーム
化学部門 1位 屋代Aチーム
理数科「課題研究」 中間発表会
11月6日(金)に、2年理数科で取り組んでいる「課題研究」の中間発表会を行いました。8月にポスターセッション形式で中間発表を行い、そこでのアドバイスなどを参考にさらに研究を進め、今回は口頭発表による中間発表を行いました。
今年の研究テーマ
(1) 最適航空路の決定


詳しくはarkheをご覧下さい。
一人一研究 中間発表会
1学年が取り組んでいる探究活動の「一人一研究」の中間発表を、5日と12日の2回に渡って実施しました。5日はクラス内でグループを作り、それぞれの研究内容について発表して質疑応答を行い、12日は他のクラスの生徒とグループを作り、パソコンを使ってPowerPointによる発表を行いました。新型コロナによる休校等で、研究の時間がなかなか確保できない中、現在までの研究の成果を熱心に発表していました。
今後は、この中間発表で得たアドバイスなどを参考にして研究のまとめの段階に入り、1月の発表会に向けて進めていきます。
5日(1回目)の様子
12日(2回目)の様子
詳しくはarkheをご覧下さい。
アカデミックサイエンス物理連携講座
10月22日(木)に、2年理数科対象の「アカデミックサイエンス」における、物理講座を実施いたしました。講師に東京大学大気海洋研究所教授の横山祐典先生をお招きし、「科学で探る過去の気候・環境」というテーマで2時間講義をしていただきました。「炭素循環」をキーワードに、年代測定に必要な放射生同位体(C14)についてなど分かりやすく説明していただきました。珊瑚が吸収したストロンチウムの量を計測することでその時代の水温がわかる話や、南極大陸の氷がすべて溶けると、海水面が60mも上昇する話など、とても興味深い内容でした。
詳しくは、alkheをご覧下さい。
arkhe158.pdf
サイエンス・ラボ
10月9日(金)と21日(水)の2日間、1年理数科対象の「サイエンス・ラボ」が実施されました。これは、SSH科目「バイオサイエンス」のプログラムとして毎年実施しているもので、長野県総合教育センターで、次の4種類の実習行いました。




詳しくは、arkheをご覧下さい。
パソコン甲子園 本選出場決定
交通安全運動 出発式
これは、松本さんが附属中学1年のときに研究をはじめ、「信号機のない横断歩道を歩行者が渡るとき、もっと車が止まるようにできるはず」と、自ら横断歩道で調査を積み重ね、高校1年の「一人一研究」、2年の「課題探究」の活動において、膨大なデータを分析し、JAF長野支部とも連携して80ページにもなる研究レポートをまとめ、「みんなで手を上げよう!キャンペーン」などの具体策を考えるなど精力的に活動したことが、長野県警に評価されたことで実現しました。長年にわたる探究活動の成果です。
NBS長野放送 ニュース
https://www.nbs-tv.co.jp/news/articles/2020091800000001.php
課題探究・課題研究 中間発表会
8月26日(土)に、2学年で取り組んでいる「課題探究(普通科)」「課題研究(理数科)」の中間発表会を、ポスターセッション形式で実施しました。今年度は学校休校などにより、探究活動をする時間が満足に確保できませんでしたが、8月の集中探究活動期間などを利用して、今回の中間発表会に臨みました。今年も様々なテーマの発表があり、熱心に自分たちの研究成果を説明していました。
信州大学教育学部から伊藤冬樹先生にもご参加していただき、時間が終わるまでアドバイスをいただきました。最後の講評では、「もう一度自分の研究を見つめ直すことが大切」と、今後の進め方についてのヒントをいただきました。
今後も探究活動を進め、12月にはレポートをまとめ、3月に口頭発表を行う予定です。
詳しくは、arkheをご覧下さい。






























